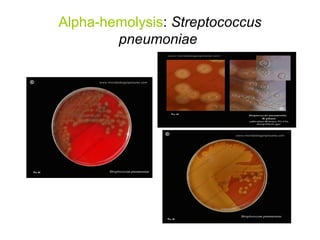
Alpha-hemolysis: Streptococcus
pneumoniae
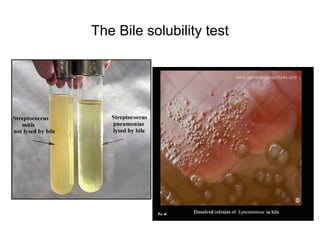
The Bile solubility test
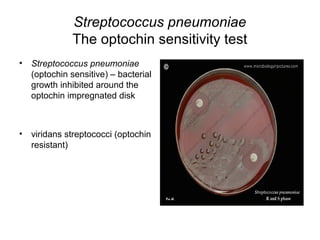
Streptococcus pneumoniae
The optochin sensitivity test
• Streptococcus pneumoniae
(optochin sensitive) – bacterial
growth inhibited around the
optochin impregnated disk
• viridans streptococci (optochin
resistant)
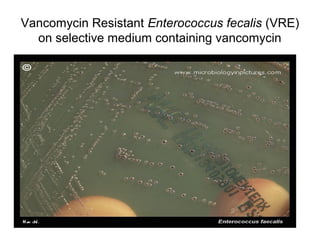
Vancomycin Resistant Enterococcus fecalis (VRE)
on selective medium containing vancomycin
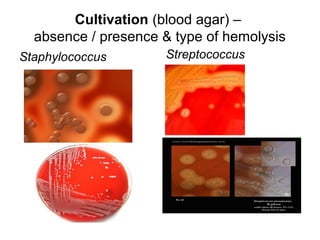
Cultivation (blood agar) –
absence / presence & type of hemolysis
Staphylococcus Streptococcus

The document outlines the bacteriological diagnosis of infections caused by specific genera of bacteria, mainly Staphylococcus and Streptococcus. It details the classification of streptococci based on hemolysis and antigenic structure, emphasizing clinically significant species like Streptococcus pyogenes and Streptococcus pneumoniae, along with their respective diagnosis methods. Specific diagnostic steps, including specimen collection, culture inoculation, and identification tests, are also described for effective determination of infections.